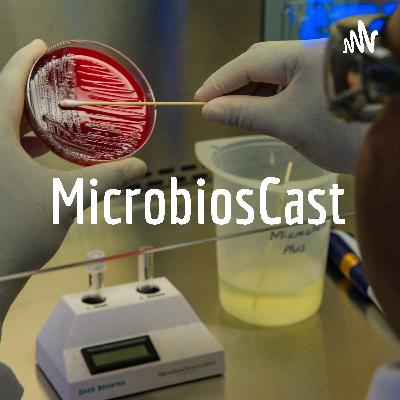
Parasitas intestinais com manifestações cutâneas🤔

Discover
Superbug.UnB
Superbug.UnB
Author: Superbug.UnB
Subscribed: 3Played: 2Subscribe
Share
© Superbug.UnB
Description
O Superbug.UnB é um projeto de extensão universitária vinculado ao curso de Farmácia da Universidade de Brasília (UnB). É um PodCast ímpar, que aborda de forma lúdica e didática conhecimentos Parasitológicos e Microbiológicos.
Superbig.UnB conduz o ouvinte a saga: "Micróbios fantásticos e onde habitam”. Aqui, micro-organismos patogênicos tem seus perfis de resistência e virulência desvendados. Certeza que você aprenderá sem estresse, sobre essas "criaturas" microscópicas, suas relações ecológicas, patogenicidade, diagnóstico e abordagens terapêuticas.
Por favor, ajude nosso podcast vitalizar,
Superbig.UnB conduz o ouvinte a saga: "Micróbios fantásticos e onde habitam”. Aqui, micro-organismos patogênicos tem seus perfis de resistência e virulência desvendados. Certeza que você aprenderá sem estresse, sobre essas "criaturas" microscópicas, suas relações ecológicas, patogenicidade, diagnóstico e abordagens terapêuticas.
Por favor, ajude nosso podcast vitalizar,
22 Episodes
Reverse
O Microbioscast adora conversar com vocês sobre vermes, né! Estreando a 4° temporada, sempre com os melhores podcasts sobre Parasitologia médica do Brasil: Parasitas intestinais com manifestações cutâneas🤔 - Neste episódio falaremos sobre o estudante de Farmácia Kelvyn Magalhaes Lopes Rocha faz um "pot-pourri" sobre vermes (Helmintos) que infectam humanos e tem habitat no intestino, mas causam manifestações cutâneas que podem ser um sinal para quem está infectado; então, se liga neste Podcast e vamos aprender e compartilhar saberes.
Este Podcast está super demais e garantimos: ninguém conversa sobre parasitologia como o Microbioscast. Escuta e comprova!
Autoria (roteiro, sonoplastia e criatividade):
Kelvyn Magalhaes Lopes Rocha
* Turma 2/2022 Fundamentos de Parsitologia.
*** O Microbioscast é vinculado ao Projeto de extensão universitária SUPERBUG.UNB (nos siga no Instagram), coordenado pela profa. Dra. Fabiana Brandão.
Pediculus humanus capitis, Pediculus humanus corporis e Pthirus pubis em Os vampiros🧛🏻♂️ que se mordam🦷 !
Pera aí! Vampiros existem? Como assim?
Pois é pessoal, neste episódio vocês vão atestar que vampiros existem sim, e podem estar bem próximos de cada um de nós, ui que medo!!!!
Escuta este Podcast sobre alguns ectoparasitas bem estranhos que "sugam" sangue e podem se espalhar e causar surtos até mesmo em hotéis!
Se liga no Microbioscats, o melhor Podcast de Parasitologia humana.
* Projeto de extensão universitária @superbug.unb -
*Metodologia Ativa de ensino da disciplina Fundamentos de Parasitologia - curso de Farmácia /FS UnB
Autoria (roteiro, sonoplastia e criatividade):
Calebe de Souza Martins
Igor Lima Cardoch Valdez
Nada Jabbour
Nathália Alves Carneiro
* Turma 1/2022
Coordenação: Profa. Dra. Fabiana Brandão
O Microbioscast não para de impressionar! A 3° temporada está realmente incrível, com os melhores Podcast sobre Parasitologia médica do Brasil:
Estrelando mais um mega sucesso do canal: Halicephalobus gingivalis em: "a queda" de um organismo!
Neste episódio polêmico ensinaremos sobre o parasito Halicephalobus gingivalis, embora seja um parasita facultativo de cavalos e até humanos, sua infecção, quando estabelecida no hospedeiro, é altamente fatal!
Neste episodio viajaremos para dento do hospedeiro infectado, passaremos por aspectos imunológicos das células de defesa, tratamento e o triste desfecho indesejado. A alegoria é contada de forma lúdica, pelo olhar do patógeno e suas estratégias para garantir sucesso na infecção.
Ah, fala sério! Este Podcast está super demais, e garantimos: ninguém discute parasitologia como o Microbioscast. Escuta e comprova 💪
Autoria (roteiro, sonoplastia e criatividade):
Beatriz Monferrari
Sara Araújo
Sarah Giovanna
Walyson Queiroz
* Turma 1/2022
Coordenação: Profa. Dra. Fabiana Brandão.
Estreando a 3° temporada do MELHOR Podcast sobre Parasitologia médica do Brasil:
The best Podcast ever sobre o tema!
Microbioscast apresenta: Como sobreviver a um ataque ameboide?
Vocês já ouviram falar dos protozoários Amebas? Elas parecem tão inofensivas né! Mas cuidado!!!! Algumas são altamente patogênicas.
Escuta nosso episódio e aprenda sobre a ameba de vida livre: Naegleria fowleri.
Projeto de extensão universitária @superbug.unb
Metodologia Ativa de ensino da disciplina Fundamentos de Parasitologia - curso de Farmácia /FS UnB
Autoria (roteiro, sonoplastia e criatividade):
Hellen Iasmin Oliveira
Daniela Machado
Isabela Tolentino
* Turma 1/2022
Coordenação: Profa. Dra. Fabiana Brandão
O Microbioscast, vinculado ao projeto de extensão Superbug.UnB, tem o compromisso de trazer ciência aos ouvidos sedentos por conhecimento.
Neste episódio os estudantes do curso de Farmácia/FS/UNB trazem um "curta" em formato de alegoria, bem divertida, sobre a famigerada vacina BCG.
Este episódio está "recheado" de ciência, história, informações importantes, e claro, aquela "pegada" típica dos nossos Podcasts, linguagem simples, mas sem perder a ciência por trás.
Créditos:
Ariana Julia Silva dos Santos de Oliveira
Glenda Macedo Mota
João Francisco Barros Morais
* Disciplina Diagnóstico Laboratorial de Microbiologia Clínica - Turma 2/2021
Supervisão:
Profa. Dra. Fabiana Brandão - Departamento de Farmácia/UnB.
Profa. Dra. Tanise Dalmolin - Departamento de Farmácia/UnB.
O Microbioscast, vinculado ao projeto de extensão Superbug.UnB, tem o compromisso de trazer ciência aos ouvidos sedentos por conhecimento. Neste episódio os estudantes do curso de Farmácia/FS/UNB trazem uma conversa bem esclarecida sobre uma doença ainda muito negligenciada, embora seja de impactante endemicidade no Brasil. A Doença de Chagas tem um marcante histórico no país, pois foi aqui que seu ciclo foi desvendado por um cientista brasileiro, Carlos Chagas. Este episódio está "recheado" de ciência, história, informações importantes, e claro, aquela "pegada" típica dos nossos Podcasts, linguagem simples, mas sem perder a ciência por trás.
Créditos:
-Larissa Oliveira Lopes;
-Matheus Sevilha;
-Luís Eduardo;
-Luana Rossi;
-Edmilson Júnior;
- Laís Siqueira de Jesus
- Mayara Silva
- Ellen Monteiro
- Leonardo Matheus
* Disciplina Fundamentos de Parasitologia - Turma 2/2021
Supervisão: Profa. Dra. Fabiana Brandão - Departamento de Farmácia/UnB.
Olá a tod@s, Está no ar mais um divertido e super informativo, MICROBIOSCAST. Será possível colocar um fungo no banco dos réus? Pois é, desta vez no Microbioscast teremos um julgamento, a levadura Candida albicans. Acho que desta vez vai dar ruim para a Candida, pois o juíz é Farmacêutico (hehehe). Estudante/Autores: Brenda de S. Moreno (Juiza),
Letícia de A. Nascimento (Vítima),
Natália Almeida (C. albicans),
Caio de Azevedo Lima ( Advogado de defesa).
Tema: Micologia Médica: Candidíase. Projeto de extensão universitária @Superbug.UnB Coordenadora geral: Profa. Dra. Fabiana Brandão. Disciplina: Diagnóstico de Microbiologia Clínica. Turma 1/2021.
Olá a tod@s,
Está no ar mais um divertido e super informativo, MICROBIOSCAST.
Neste episódio o "Tá especulando" - A dupla mais curiosa do mundo da PA RA SI TO LO GIIIIAAA, explicará o que são Taenia spp., as famosas "solitárias" e quais doenças causam, como evitar e como tratar.
Além disso, conversaremos sobre aspectos curiosos do ciclo evolutivo e processo infeccioso desses vermes platelmintos da classe cestoda.
Estudante/Autores:
Beatriz Martins Ferraris
Letícia França Pereira
Natanael Carvalho de Souza
Thaís Souza da Silva
Tema: Taenia saginata & Taenia solium
Projeto de extensão universitária @Superbug.UnB
Coordenadora geral: Profa. Dra. Fabiana Brandão.
Disciplina: Fundamentos de Parasitologia Clínica.
Turma 1/2021.
Olá pessoal conectado no nosso canal Microbioscast. É ótimo ter você aqui para ouvir mais um dos nossos famosos PodCasts.
Atenção! Comunicado URGENTE!
Interrompemos sua programação local para uma notícia urgente, um parasito chega ao planeta terra e está causando "dor de cabeça" aos moradores em todas as regiões, há um grande número de assintomáticos, mas, os mais afetados sintomaticamente são crianças e também pessoas em situações de baixa renda e moradores rurais, distribuídos pelas regiões tropicais e temperadas do mundo...... 1 segundo... recebemos a notícia da Terra-616 que os Eliminadores (vulgo Vingadores) tem todas as informações sobre o parasito, lá esta doença já está erradicada. Vamos direto para o local, onde está acontecendo uma reunião entre eles. Bom dia e se cuidem.
Estudante/Autores:
Nahan Nunes Silva
Karoliny Marques do Carmo Santana
Sofia Alves Monteiro Carvalho
Tema: Ascaris lumbricoides & Ascaridíase.
Projeto de extensão universitária @Superbug.UnB
Coordenadora geral: Profa. Dra. Fabiana Brandão.
Disciplina: Fundamentos de Parasitologia Clínica.
Turma 1/2021.
Olá pessoal que está conectado no nosso canal Microbioscast. É muito bom ter você aqui para ouvir mais um dos nossos famosos PodCasts.
Neste Podcast, uma convidada ilustre, a entrevistadora "Marília Gabriela" (versão da Farmácia / UnB) bate-papo cm os inusitados Bacilos Gram-negativos NÃO Fermentadores. O episódio está hilário e cheio de curiosidades, como: virulência e perfil de resistência/susceptibilidade dessas bactérias, além de uma divertida “intriga'. coisa antiga, dessas bactérias com as Gram-negativas Fermentadoras.
Ao final, a Gabi também conversa com o Ácido Clavulânico.
Acredite! Vc irá aprender Microbiologia Clínica "chorando" de tanto rir! O episódio mais engraçado da Temporada 1 de Microbioscast está disponível AGORA para você.
Estudante/Autores:
Caroline Moraes Tosta
Jefferson Rodrigo dos Santos Melo
João Lucas da Silva Correia
Saulo de Tarso Silva
Tema: Bactérias Gram Negativas Fermentadoras
Projeto de extensão universitária @Superbug.UnB
Coordenadora geral: Profa. Dra. Fabiana Brandão.
Disciplina: Diagnóstico Laboratorial de Microbiologia Clínica.
Olá a todos, sejam muito bem-vindos ao programa MicrobiosCast na “Manhã com o Parasito”! Hoje teremos alguns convidados excepcionais. Entrevistaremos 2 parasitos causadores da Malária, que pertencem ao gênero Plasmodium, seu vetor biológico, o mosquito Anopheles (N) darlingi e claro, um profissional da saúde, uma farmacêutica Top, da UnB claro, que irá falar um pouco sobre fármacos para tratamento da Malária.
Autores:
Estudantes de Farmácia (UnB)
Ana Cecília de O. Souza,
Brenda de S. Moreno
Camila Gabrielle
Jéssica W. Ferreira
Letícia de A. Nascimento
Letícia Guimarães C. Moreira
Lívia Stéffany X. Soares
Projeto de extensão universitária Superbug.UnB
Coordenador geral: Profa. Dra. Fabiana Brandão.
Entrevista de Emprego na Parasito’s Building
(Narrador): Faaaaaaaala, meus queridos hospedeiros! Tudo bem com vocês? Meu nome é Maria Flebotomíneo e hoje nós começamos mais um MicroCast e eu tô bem ansiosa para mostrar uma história pra vocês. É sobre uma entrevista de emprego de dois parasitos bem conhecidos na empresa mais amada do Brasil, mas eu não vou dar spoiler, vocês vão ter que escutar até o final.
A empresa da qual eu falo é a Parasito’s Building, empresa renomadíssima (falar com ênfase), e que precisava u-r-g-e-n-t-e-m-e-n-t-e contratar mais um parasito para compor seu quadro de funcionários porque queriam crescer no mercado da parasitologia. Ai, gente, capitalismo né. Não tá fácil pra ninguém. Sem mais delongas, bora começar a história!
Em mais um fatídico dia útil na empresa, os CEO’s Morfologia, Ciclo biológico, Clínica e diagnóstico, e Profilaxia e Tratamento, se encontravam na sala principal, que se localizava no intestino, à espera de dois parasitos para uma entrevista de emprego. Quem será que vai se sair bem na pergunta que todos os setores vão fazer? Joguei a bomba e saí correndo.
E tudo começou assim… Alunos: Ana Lívia Sales, Camila Yamamoto, Christiane Pereira, Gabriel Lucas, Ingrid Araújo, Isabela Moreira e Lucas Luiz. Narrador - Christiane Morfologia - Ingrid Ciclo Biológico - Camila Diagnóstico/Clínica - Isabela Tratamento/Profilaxia - Gabriel L. amazonensis - Lucas L. infantum - Ana Lívia.
MicrobiosCast - Ep#3 - Resistência aos Antifúngicos - PodCast elaborado na disciplina Diagnóstico Laboratorial de Microbiologia Clínica, do Departamento de Farmácia, da Universidade de Brasília. Autores: Paulo Jose Ferreira de Freitas, THÁSSIA ALMEIDA DE OLIVEIRA, Luane Oliveira & Marcello Augusto de Castro Coutinho Araujo.
MicrobiosCast - Ep#2 - Esse PodCast é uma entrevista com o bacilo gram negativo, nele falamos que ele é uma bactéria em forma de bastonete, de que sua parede celular é formada, como ele consegue infectar a célula saudável, explicamos também a importância de suas estruturas, falamos sobre cada mecanismo de ação de resistência a antimicrobianos.
MicrobiosCast - Ep#1 - Dentro do gênero Mycobacterium as espécies responsáveis por causar a tuberculose e hanseníase são as mais conhecidas e estudadas, no entanto, também é necessário dar uma atenção especial as Micobactérias Não Tuberculosas (MNT), objetivo desse PodCast. Pelo caráter oportunista desses patógenos, houve um aumento exponencial da doença na década de 90 com o surto de casos de HIV, devido uma população crescente de indivíduos vulneráveis. Além disso, infelizmente ainda é comum notícias de procedimentos estéticos ou cirúrgicos que acabam culminando com uma infecção por micobaceterioses. Dito isso, o objetivo desse PodCast foi reunir o máximo de informações sobre as formas de contágio, como é feito o diagnóstico da doença, quais as técnicas laboratoriais utilizadas para identificar esse microrganismo e como é realizado o tratamento.
Uau! Neste episódio vamos falar sobre um protozoário muito importante para a saúde pública, especialmente aqui no Brasil. Estreando os novos episódios do Superbug.UnB, agora com participação de convidados especiais, temos neste episódio a ilustre participação do professor Dr. Carlos André Ornelas Ricart, um dos grandes cientistas que estuda Doença de Chagas Venha conferir nesse episódio o quão significativa foi a obtenção de dados a partir da proteômica do Trypanosoma cruzi em estudos pioneiros no território nacional e, a partir disso, entender como essas informações ajudaram na melhor compreensão da doença de Chagas e na especulação de possíveis caminhos para o desenvolvimento do que pode vir a ser uma vacina. Se despertar o seu interesse, escute! Se gostar do nosso conteúdo, pedimos que compartilhe ! Se tiver algo para dizer, deixe um comentário com sua opinião!! Ficaremos gratos em receber esse feedback!! Projeto de extensão universitária @superbug.unb - Metodologia Ativa de ensino da disciplina Fundamentos de Parasitologia- Curso de Farmácia/FS Universidade de Brasília/UnB Autoria (Roteiro, criação, efeitos sonoros e edição) 1. Elcio Ferreira Frota Junior 2. João Augusto Pacheco da Cruz 3. Kauã Soares Alves Convidado especial: Prof. Dr. Carlos André Ornelas Ricart (UnB) *Turma 1/2025 Coordenação: Profa. Dra. Fabiana Brandão
Caramba! Um mistério intrigante que o Sherlock teve que desvendar no Brasil. Mas tenho certeza que após escutar este podcast super informativo e totalmente divertido, você também irá resolver outros mistérios similares.
Escuta, compartilha e deixa um comentário pra gente ❤️
Nossos podcasts são gratuitos, feitos com esmero e cuidado pelos estudantes de Farmácia/UnB.
Projeto de extensão universitária @superbug.unb - Metodologia Ativa de ensino da disciplina Fundamentos de Parasitologia - curso de Farmácia /FS
Universidade de Brasília/UnB
Autoria (roteiro, criação, criatividade e sonoplastia):
1. Luciane Andrade Figueiredo Silva,
2. Andressa das Chagas Ferreira
* Turma 2/2024
Coordenação:
Profa. Dra. Fabiana Brandão
Escuta, compartilha e deixa um comentário pra gente ❤️
Nossos podcasts são gratuitos, feitos com esmero e muito cuidado pelos estudantes de Farmácia/UnB.
Projeto de extensão universitária @superbug.unb - Metodologia Ativa de ensino da disciplina Fundamentos de Parasitologia - curso de Farmácia /FS
Universidade de Brasília/UnB
Autoria (roteiro, criação, criatividade e sonoplastia):
Jennifer Martins do Nascimento,
João Vitor Tomé Alcântara,
Luizete da Silva Cordeiro,
Vitoria Waynne Vitorino Costa
* Turma 1/2023
Coordenação:
Profa. Dra. Fabiana Brandão
Projeto de extensão universitária SUPERBUG.UNB apresenta: Esquistossomose🐌: guerra ⚔️ infinita!
Olá curiosos! Que tal aprender, mas aprender mesmo, tudinho sobre a Esquistossomose?
Sabia que esse verme é um platelminto?
Sabe quem é o vetor biológico dele?
Sabe como é o ciclo e formas de tratamento no SUS?
Quer saber isso e muito mais, escuta este Podcast sensacional e aprenda de forma divertida, simples e rápida.
Projeto de extensão universitária @superbug.unb - Metodologia Ativa de ensino da disciplina Fundamentos de Parasitologia - curso de Farmácia /FS UnB
Autoria (roteiro, sonoplastia e criatividade):
Pedro Henrique Felizardo Silva,
Mikaely de Sousa Nunes,
Mônica Shigemi Souza Mori
* Turma 1/2023
Coordenação: Profa. Dra. Fabiana Brandão.
Projeto de extensão universitária SUPERBUG.UNB apresenta: O gato🐈 não é o vilão: Toxoplasmose, já passou da hora de você aprender sobre!
E a Toxoplasmose hein! O que anda rolando sobre o assunto? Será que as gestantes devem mesmo evitar seus gatinhos? Será como a pessoa contrai essa infecção?
Escuta este Podcast e você sairá sabendo mais do que pensa!
Projeto de extensão universitária @superbug.unb - Metodologia Ativa de ensino da disciplina Fundamentos de Parasitologia - curso de Farmácia /FS UnB
Autoria (roteiro, sonoplastia e criatividade): Aline Correia, Anne Beatriz, Jennifer Soares, Maysa Godoy.
* Turma 1/2023
Coordenação: Profa. Dra. Fabiana Brandão